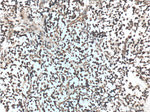
Presenilin-1 Antibody in Immunohistochemistry (Paraffin) (IHC (P))

Search
Proteintech
Presenilin-1 Polyclonal Antibody
{{$productOrderCtrl.translations['antibody.pdp.commerceCard.promotion.promotions']}}
{{$productOrderCtrl.translations['antibody.pdp.commerceCard.promotion.viewpromo']}}
{{$productOrderCtrl.translations['antibody.pdp.commerceCard.promotion.promocode']}}: {{promo.promoCode}} {{promo.promoTitle}} {{promo.promoDescription}}. {{$productOrderCtrl.translations['antibody.pdp.commerceCard.promotion.learnmore']}}
图: 1 / 7
Presenilin-1 Antibody (16163-1-AP) in IHC (P)

产品信息
16163-1-AP
种属反应
已发表种属
宿主/亚型
分类
类型
抗原
偶联物
形式
浓度
规格
纯化类型
保存液
内含物
保存条件
运输条件
产品详细信息
This antibody is specific to isoform 1 (53 kDa), isoform 2 (52 kDa), isoform 4 (21 kDa), isoform 7 (49 kDa) of this protein.
靶标信息
Presenilin1 was initially identified a marker of susceptibility to early-onset Alzheimer's disease. In addition to PEN2, nicastrin and APH-1, Presenilin1 forms the -gamma-secretase protein complex, a membrane-bound aspartyl protease that can cleave certain proteins at peptide bonds buried within the hydrophobic environment of the lipid bilayer. This cleavage is responsible for a key step in signaling from several cell-surface receptors and is thought to be required for the generation of the neurotoxic amyloid peptides that are central to the pathogenesis of Alzheimer's disease. Like the tumor necrosis factor-alpha-converting enzyme (TACE) and the beta-site cleavage enzyme (BACE) protease families, -gamma-secretase will cleave the amyloid precursor protein (APP), but within the intramembrane region of APP, resulting in either the non-toxic p3 (from the alpha and -gamma cleavage site) or the toxic Abeta amyloid peptide (from the beta and -gamma cleavage site). It is thought that accumulation of the Abeta peptide is the precursor to Alzheimer's disease. Multiple isoforms of presenilin1 are known to exist.
仅用于科研。不用于诊断过程。未经明确授权不得转售。
生物信息学
蛋白别名: Alzheimer Disease 3; familial Alzheimer Disease; Minilin; Presenilin-1; presenilin1; Protein S182; PS-1; S182; S182 protein; Senilin 1; unnamed protein product
基因别名: ACNINV3; AD3; Ad3h; CMD1U; FAD; PS-1; PS1; PSEN1; PSNL1; S182
UniProt ID: (Human) P49768, (Rat) P97887, (Mouse) P49769
Entrez Gene ID: (Human) 5663, (Rat) 29192, (Mouse) 19164



